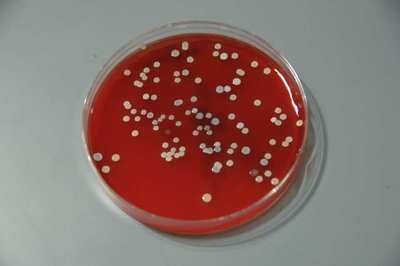

16 Crazy Facts That Will Blow Your Mind
11. The strongest creature on earth

Gonorrhea is the strongest creature in the world. They can pull the force equal to 100,000 their weight.
Share this!

Gonorrhea is the strongest creature in the world. They can pull the force equal to 100,000 their weight.
